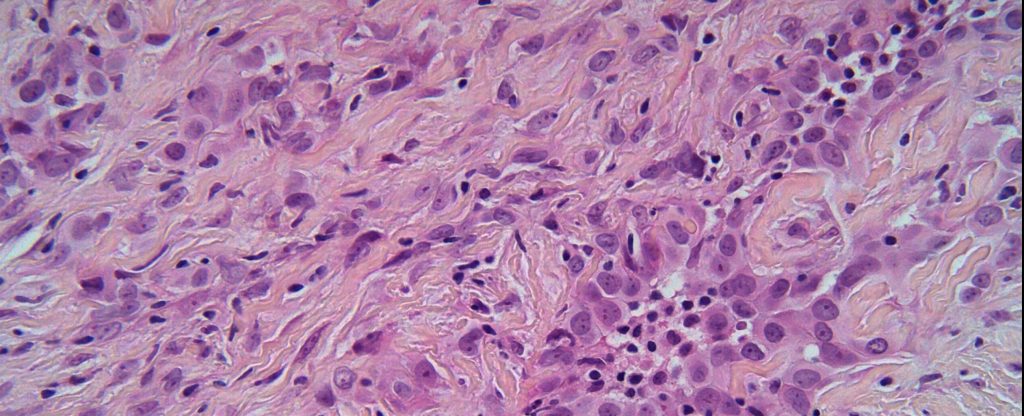

cncpt-artikel_lb_atf
Patients with malignant pleural mesothelioma continue to benefit from immunotherapy combination
CheckMate 743 study confirms that combination treatment with nivolumab and ipilimumab prolongs overall survival in patients with unresectable malignant pleural mesothelioma